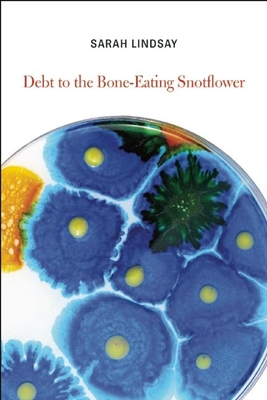
Debt to the Bone-Eating Snotflower 1556594461 Book Cover

All Formats & Editions
1 - 1 of 1 results found
Debt to the Bone-Eating Snotflower
Edition Description
"Sarah Lindsay's poems open doors to other worlds and other ways of seeing."--The New York Times
Edition Details
Format:Paperback
Language:English
ISBN:1556594461
Format: Paperback
Condition:
$
8.19
Save $7.81!
List Price: $16.00
Almost Gone, Only 1 Left!



